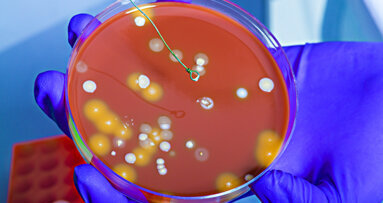
Study: Bib clips can harbor bacteria even after disinfection

OXNARD, Calif., USA: Researchers at Tufts University School of Dental Medicine, in collaboration with researchers at the Forsyth Institute, have published a study that found 20 to 30 percent of dental bib clips still harbor bacterial contaminants even after proper disinfection procedures. Rubber-faced metal bib clips were found to retain more bacteria than bib clips made only of metal before disinfection.
The study also found that before disinfection, bib clips used during orthodontic procedures had three times the bacterial load of those used during endodontic procedures, suggesting that the nature of dental treatment impacts the number of bacteria present on the clips.
The study is believed to the first peer-reviewed study to be published on bib clip contamination. Four other research reports have found bacterial contamination on dental bib holders, including research conducted by U.S. infection control specialist Dr. John Molinari, the University of North Carolina at Chapel Hill’s School of Dentistry Oral Microbiology lab and the University of Witten/Herdecke in Germany.
“Our study included statistical analysis and, to the best of our knowledge, is the most comprehensive study to date analyzing the bacterial load on dental bib clips before and after disinfection in two specialized clinics,” said Addy Alt-Holland, MSc, PhD, assistant professor at Tufts University School of Dental Medicine and the lead researcher on the study. “The study found that disinfecting reduced bacterial contamination by 92 percent but some bacteria remained on several bib clips even after disinfection. Further research is underway to identify the bacterial species in samples from both pre- and post-disinfected bib clips to determine whether or not they retain disease-causing bacteria and if they pose contamination risks.”
The study analyzed bacterial loads on bib clips from a total of 80 dental bib holders — 40 collected from Tufts University School of Dental Medicine’s endodontics clinic and another 40 collected from the school’s orthodontics clinic. From each chain, both clips that hold the dental bib were sampled before and after practitioners disinfected the bib holder following the school’s disinfection protocol, which requires the holder to be wiped down with an EPA-approved disinfectant wipe, according to the manufacturer’s instruction. Disinfection was found to reduce bacteria on the bib clips, but did not completely eliminate it, leaving 20 to 30 percent of the bib clips contaminated with bacteria.
Thirty percent of the metal bib clips collected from the endodontics clinic and 25 percent of those collected from the orthodontics clinic were still contaminated with bacteria after disinfection. Twenty-five percent the rubber-faced metal bib clips collected from the endodontics clinic and 20 percent of those collected from the orthodontics clinic were still contaminated with bacteria after disinfection.
“The findings of the study translate into private practice,” said Gerard Kugel, DMD, MS, PhD, professor at Tufts University School of Dental Medicine and senior author on the paper. “In a busy practice, you are doing a lot of different procedures and bringing patients in and out quickly. It is time-consuming to properly clean bib clips by autoclave, and spray is not an effective way to disinfect bib clips. If you are using bib holders, make sure the chains and clips are being disinfected after every patient, or consider moving to using disposable bib holders.”
Dr. Kugel is also associate dean for research at Tufts.
Nature of dental treatment and style of bib clips impacts level of bacteria on bib clips
When the bib clips were sampled before disinfection, the study found a significant difference in the presence of bacteria on the clips depending on which clinics the clips were sampled from and the style of the bib clip. Before disinfection, metal and rubber-faced metal bib clips collected from the orthodontics clinic had 149 percent to 205 percent more bacteria, respectively, than clips collected from the endodontics clinic.
The authors speculate that the use of rubber dams during endodontic treatment may limit the contamination of bib clips while orthodontic treatment may result in higher bacterial presence on clips since it involves entering and re-entering the mouth multiple times which could lead to more bacterial contamination from the practitioner’s gloves; or adolescent and teenage patients, common to orthodontics, may be more prone to touch and handle the bib clip during treatment. After disinfection, the bacterial counts on clips from both clinics were similarly reduced.
Before disinfection, rubber-faced metal bib clips were found to have more than double the number of bacteria on average than metal clips had.
“The surface of rubber and metal is different in composition and may explain the difference in bacterial loads on them,” Dr. Alt-Holland said.
Rubber-faced metal bib clips collected from the endodontics clinic had 119 percent higher bacterial count than metal bib clips and 167 percent higher bacterial count on those from the orthodontics clinic before disinfection. After disinfection, the bacterial counts on both styles of clips were found to be similar.
Continuation study under way to identify bacteria strains
A continuation study is already under way by researchers at Tufts University School of Dental Medicine and the Forsyth Institute to identify the type of bacteria present on dental bib clips before and after disinfection to help determine if there are cross-contamination risks to patients.
The full study, titled “Do Bib Clips Pose a Cross-Contamination Risk at the Dental Clinic?” is available for download at www.duxdental.com/bibclipstudy.
(Source: DUX Dental)
CAMBRIDGE, Mass., USA: Researchers at Tufts University School of Dental Medicine and the Forsyth Institute have published a study that found a significant ...
OXNARD, Calif., USA: A recent report authored by John A. Molinari, Ph.D., and Peri Nelson, B.S., suggests that there are many advantages of using disposable...
ROANOKE, Va., USA: Three dentists have opened a practice built with special technology that is designed to reduce energy use by 70 percent. The new building...
CHICAGO: Research has shown that playing a musical instrument can help nourish, cultivate and increase intelligence in children, but playing a used ...
BUFFALO, N.Y., USA: Antidepressants, commonly used to treat anxiety, pain and other disorders, may play a role in dental implant failure, according to a new...
MINNEAPOLIS, US: Since the election of Donald Trump as US president in 2024, the question of water fluoridation in the country has become increasingly ...
NEW YORK, NY, USA: Dr Deepak Saxena, a microbiologist at the New York University College of Dentistry (NYUCD), and Dr Anup Singh, an engineer at Sandia ...
NEW YORK, N.Y., USA: Having “ugly” teeth may be a significant cause of bullying, according to a new study just published in the American Journal...
PHILADELPHIA, US: It was previously believed that Streptococcus mutans was the main microorganism responsible for dental caries. However, in a recent study,...
Richardson, Texas, USA: A recent study by faculty and students at the Medical University of South Carolina College of Dental Medicine found clinically ...
Live webinar
Mon. 6 July 2026
12:00 PM EST (New York)
Live webinar
Tue. 7 July 2026
8:00 PM EST (New York)
Dr. Mark Donaldson BSP, ACPR, PHARMD, FASHP, FACHE
Live webinar
Wed. 8 July 2026
8:00 AM EST (New York)
Live webinar
Wed. 8 July 2026
1:00 PM EST (New York)
Prof. Gianluca Gambarini MD, DDS
Live webinar
Wed. 8 July 2026
10:00 PM EST (New York)
Dr. Jae Seon Kim DDS, MSD, FACP, CDT
Live webinar
Thu. 9 July 2026
1:00 PM EST (New York)
Dr. Armando Lopes, Dr. Carlos Moura Guedes



 Austria / Österreich
Austria / Österreich
 Bosnia and Herzegovina / Босна и Херцеговина
Bosnia and Herzegovina / Босна и Херцеговина
 Bulgaria / България
Bulgaria / България
 Croatia / Hrvatska
Croatia / Hrvatska
 Czech Republic & Slovakia / Česká republika & Slovensko
Czech Republic & Slovakia / Česká republika & Slovensko
 France / France
France / France
 Germany / Deutschland
Germany / Deutschland
 Greece / ΕΛΛΑΔΑ
Greece / ΕΛΛΑΔΑ
 Hungary / Hungary
Hungary / Hungary
 Italy / Italia
Italy / Italia
 Netherlands / Nederland
Netherlands / Nederland
 Nordic / Nordic
Nordic / Nordic
 Poland / Polska
Poland / Polska
 Portugal / Portugal
Portugal / Portugal
 Romania & Moldova / România & Moldova
Romania & Moldova / România & Moldova
 Slovenia / Slovenija
Slovenia / Slovenija
 Serbia & Montenegro / Србија и Црна Гора
Serbia & Montenegro / Србија и Црна Гора
 Spain / España
Spain / España
 Switzerland / Schweiz
Switzerland / Schweiz
 Turkey / Türkiye
Turkey / Türkiye
 UK & Ireland / UK & Ireland
UK & Ireland / UK & Ireland
 International / International
International / International
 Brazil / Brasil
Brazil / Brasil
 Canada / Canada
Canada / Canada
 Latin America / Latinoamérica
Latin America / Latinoamérica
 China / 中国
China / 中国
 India / भारत गणराज्य
India / भारत गणराज्य
 Pakistan / Pākistān
Pakistan / Pākistān
 Vietnam / Việt Nam
Vietnam / Việt Nam
 ASEAN / ASEAN
ASEAN / ASEAN
 Israel / מְדִינַת יִשְׂרָאֵל
Israel / מְדִינַת יִשְׂרָאֵל
 Algeria, Morocco & Tunisia / الجزائر والمغرب وتونس
Algeria, Morocco & Tunisia / الجزائر والمغرب وتونس
 Middle East / Middle East
Middle East / Middle East

To post a reply please login or register